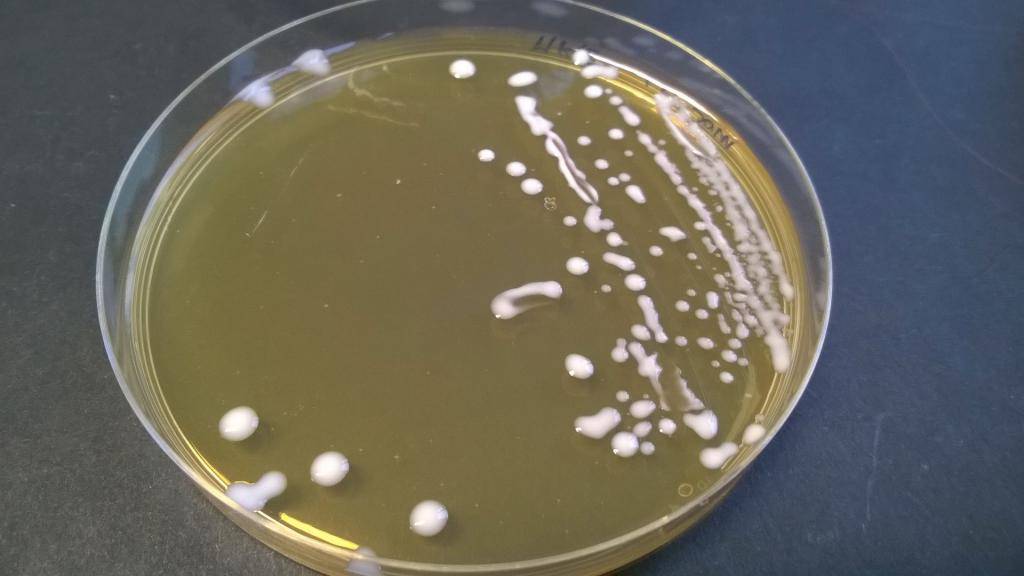

Факторы, влияющие на нормальную флору
Многие факторы влияют на стабильность микробиоты влагалища. Состав влагалищной микрофлоры может колебаться в зависимости от возраста, полового созревания, менструаций, беременности, инфекций, контрацепции и сексуального поведения.
- Воздействие спермицидов, β-лактамаз или других антибиотиков может уменьшить количество лактобацилл и, как следствие, увеличить восприимчивость к влагалищным инфекциям.
- Обсеменение влагалища происходит вскоре после или во время родов. Внутриутробно плод, как думали раньше, существует в стерильной или почти стерильной среде, но некоторые исследования показали наличие малого количества микроорганизмов в плаценте.
При родах через естественные родовые пути новорожденный подвергается воздействию разнообразных микробов. Последние исследования показывают, что новорожденные обсеменяются микроорганизмами из влагалища и прямой кишки их матерей.
Изменения в составе влагалищной флоры могут быть обусловлены гормональными сдвигами, которые происходят на протяжении всей жизни женщины.
В раннем детстве рН во влагалище нейтральная или слабо щелочная. Когда уровень эстрогена во время полового созревания нарастает, гликогена становится больше, это приводит к преобладанию бактерий, продуцирующих молочную кислоту.
Эти бактерии обладают способностью ферментировать гликоген в глюкозу и, в итоге, образовывать молочную кислоту. В результате этого снижается уровень pH, что создаёт неблагоприятную среду для многих болезнетворных, “не очень хороших” бактерий.
Традиционно высокий уровень молочнокислых бактерий считается визитной карточкой здорового влагалища, и у большинства женщин репродуктивного возраста во влагалище преобладают именно лактобактерии.
Когда у женщины наступает период менопаузы, уровень эстрогенов и гликогена уменьшается и, как следствие, снижается количество лактобактерий во влагалище. В результате всё меньше образуется молочной кислоты, а уровень рН возрастает.
Заместительная гормональная терапия во время и после менопаузы нейтрализует этот эффект и способствует значительному снижению уровня рН влагалища по сравнению с женщинами в постменопаузе.
- Состав микрофлоры влагалища существенно отличается среди женщин репродуктивного возраста различных этнических групп.
- Также динамическое равновесие влагалищной микрофлоры может быть изменено под влиянием факторов окружающей среды и внешних факторов (например, приём антибиотиков, гигиена влагалища, половые контакты, гормональная терапия и т. д.). Эти изменения могут привести к микробному дисбалансу или дисбиозу в мочеполовых путях.
В обзоре исследований, опубликованных между 1966 и 2003 годами, бактериальный вагиноз был диагностирован на основании клинической картины в 22 ̶ 50 % случаев, кандидозный вульвовагинит в 17 ̶ 39 %, трихомониаз в 4 ̶ 35 % случаев. Примерно в 30 % случаев на основании жалоб поставить диагноз не представляется возможным.
Отсутствие зуда делает диагноз кандидозного вульвовагинита маловероятным. Отсутствие специфического, неприятного, «рыбного» запаха влагалищных выделений делает неправдоподобным бактериального вагиноза.
Наличие признаков воспаления и отсутствие неприятного запаха чаще ассоциируется с кандидозным вульвовагинитом.
Для подтверждения/исключения диагноза «бактериальный вагиноз» и «вагинит», визуальной оценки нарушений микрофлоры во влагалище используют микроскопию мазков на флору (иначе — мазок на степень чистоты, мазок на GN, микроскопическое исследование отделяемого мочеполовых органов женщин (микрофлора)).
При микроскопии могут наблюдаться 4 основных картины, которые раньше называли «степени чистоты влагалища». Сейчас используют другую терминологию и классификацию, но суть исследования остается прежней.
Что входит в тест
Выявляемые показатели:
- КВМ (контроль взятия материала) – позволяет убедиться, что материал взят качественно и в образце присутствует ДНК человека (есть материал из влагалища и шейки матки)
- ОБМ (общая бактериальная масса)- сколько всего микроорганизмов в вагинальном секрете.
Нормальная флора:
- Lactobacillus spp. -показывает общее количество нормальных лактобактерий
- Условно-патогенные микоплазмы:
- Mycoplasma (hominis);
- Ureaplasma (urialiticum+parvum);
Их выявление не всегда означает заболевание, в небольших количествах они могут быть и у абсолютно здоровой женщины.
Candida spp.- дрожжеподобные грибы, при их размножении развивается одно из самых популярных гинекологических заболеваний, часто называемое “молочницей».
Факультативно-анаэробные микроорганизмы:
- Enterobacterium spp.;
- Streptococcus spp.;
- Staphylococcus spp.;
Могут расти на воздухе и без присутствия кислорода. Присутствуют и в норме и при некоторых заболеваниях, количественная оценка позволяет понять их роль у каждой конкретной пациентки.
Анаэробы:
- Gardnerella vaginalis;
- Prevotella bivia;
- Porphyromonas spp.;
- Eubacterium spp.;
- Sneathia spp.;
- Leptotrichia spp.;
- Fusobacterium spp.;
- Megasphaera spp.;
- Veillonella spp.;
- Dialister spp.;
- Lachnobacterium spp.;
- Clostridium spp.;
- Mobiluncus spp.;
- Corinebacterium spp.;
- Peptostreptococcus spp.;
- Atopobium vaginae;
Эти микроорганизмы не растут в присутствии кислорода, обычные посквы из влагалища их не выявляют. Только тест фемофлор позволяет не только их выявить, но и определить их количество. Ведь они могут быть и у здоровой женщины, весь вопрос в количестве.
Патогенные микроорганизмы:
Mycoplasma genitalium- в отличие от микоплазмы хоминис, это безусловный враг, ее быть не должно.
ВЕНЕРИЧЕСКИЕ ИНФЕКЦИИ( хламидия, гонорея, трихомонада) НЕ ВХОДЯТ В СОСТАВ ДИАГНОСТИЧЕСКОГО ТЕСТА ФЕМОФЛОР-16, для их диагностики предназначен тест фемофолор-13, фемофлор-скрин, флороценоз и стандартные ПЦР тесты, которыми обычно дополняется тест фемофлор-16.
Также фемофлор-16 не определяет вирусы герпеса, папилломы человека, цитомегаловирус.
Фемофлор 16 — высокоинформативный анализ биологического материала из канала шейки матки и влагалища. Лабораторный мониторинг позволяет оценить соотношение полезных молочнокислых бактерий, условно–патогенных и патогенных микроорганизмов, которые живут в цервикальной слизи и вагинальном секрете. Микрофлору исследуют с помощью ПЦР-диагностики. Полимеразная цепная реакция в режиме реального времени помогает достоверно определить бактериальную массу, а затем дать количественную оценку всевозможным бациллам, коккам, грибкам и вирусам, которые обитают и размножаются на слизистой гениталий у женщины.
Мазок на флору
Расшифровать мазок на флору должен лечащий врач, но некоторую информацию можно получить самостоятельно еще до приема.
О чём может рассказать мазок на флору?
Рассмотрим подробнее, какими могут быть результаты анализов и что это значит.
Смешанная флора в мазке
Возникает в таких случаях:
- начало или конец менструального цикла;
- климактерический период;
- наличие венерических заболеваний;
- гиперфункция яичников;
- начало полового созревания у девочек.
Для определения точной причины наличия смешанной флоры в мазке необходимо оценить количество лейкоцитов и провести дополнительные исследования.
Палочковая флора в мазке
Палочки бывают двух типов:
- Морфотип лактобактерий (палочки Дедерлейна).
- Мелкие палочки.
Много палочек первого типа во флоре является нормальным показателем здорового организма. При этом в поле зрения наблюдаются единичные лейкоциты или их количество не превышает 10 штук на квадратный сантиметр.
Наличие мелких палочек говорит о таком заболевании как гарднереллез или о дисбактериозе влагалища.
Лактобациллярная флора в мазке
Лактобациллы является нормальной составляющей здоровой микрофлоры
При расшифровке анализа необходимо обратить внимание на концентрацию лейкоцитов и эритроцитов, а также их соотношение с количеством лактобацилл
Коккобациллярная флора в мазке
Такой результат обычно сочетается с повышенным содержанием лейкоцитов и практически полным отсутствием палочек Дедерлейна. Выделения из влагалища имеют густую слизистую структуру с неприятным запахом. Коккобациллярная флора встречается в 2-х случаях:
- Бактериальный вагиноз.
- Венерические заболевания.
Часто эти причины взаимосвязаны между собой и требуют специального лечения, иногда с применением антибиотиков.
Отсутствие флоры в мазке
Результат исследования такого типа встречается крайне редко и может означать, что перед сдачей мазка организм длительное время подвергался лечению антибактериальными препаратами в больших дозировках. Это приводит к вымиранию нормальных составляющих флоры, особенно лактобацилл, которые придется восстанавливать под наблюдением врача.
Мазок на патогенную кишечную флору
Данный вид анализа берется либо из влагалища, либо из прямой кишки. Из-за тесной взаимосвязи кишечника и детородных органов женщины, а также их близкого расположения, возбудители инфекций могут быстро распространяться из влагалища на стенки кишечника и наоборот.
Правила сдачи мазка на флору:
- Избегать половых контактов за двое суток до взятия мазка.
- Не принимать ванну.
- Не делать спринцеваний.
- Не пользоваться вагинальными таблетками, свечами и тампонами.
- За 3 часа до взятия мазка перестать посещать туалет.
- Подмываться перед сдачей анализа нужно исключительно теплой водой, без средств гигиены.
- Не сдавать мазок непосредственно во время месячных, а также в самом начале и конце менструального цикла.
Если мазок берется из носоглотки, правила следующие:
Что представляют собой лактобактерии?
Лактобактерии относятся к естественной микрофлоре организма. Они необходимы для обеспечения нормального метаболизма, поэтому находятся внутри нас постоянно. Средой обитания лактобактерий является весь пищеварительный тракт, а также наружные половые органы у женщин. Эти микроорганизмы могут приобретать различную форму, чаще всего они встречаются в виде палочек. Лактобациллы относятся к Грам (+) и анаэробным бактериям, они неспособны к образованию спор. Эти микроорганизмы относятся к группе молочнокислых палочек, благодаря своей способности перерабатывать лактозу и прочие углеводы. В процессе своего метаболизма они выделяют лизоцим – обеззараживающее вещество, перекись водорода и другие продукты обмена, обладающие антибиотической активностью. Основное их свойство – образование молочной кислоты, которая препятствует развитию и размножению патогенных бактерий и грибов.
Лактобациллы в большом количестве обитают на слизистой оболочке внутренних органов. Они распространены по всему пищеварительному тракту, начиная с ротовой полости. Далее Lactobacillus spp переходят на слизистую оболочку глотки, пищевода, желудка и кишечника. Местом их наибольшего скопления является конечный отдел пищеварительного тракта. Это объясняется тем, что в толстом кишечнике находятся специальные клетки – энтероциты, взаимодействие с которыми обеспечивает процессы репарации слизистой оболочки, формирование защитных сил организма посредством образования лизоцима и специальных иммуннокомпетентных клеток (цитокинов). Ещё одним местом обитания Lactobacillus spp является вульва и влагалище. Присутствие лактобактерий на наружных половых органах у женщин необходимо для защиты слизистой оболочки от патогенных факторов и обеспечения препятствия для попадания инфекции внутрь.
В женском организме лактобактерии находятся в большем количестве по сравнению с биоценозом у мужчин. Так как половые органы девочек являются открытыми воротами для различных инфекционных агентов, то там необходимо наличие Lactobacillus spp. Норма у женщин составляет — 10 6 — 10 9 КОЕ/мл. Если в мазках с вульвы, влагалища и уретры обнаружены данные показатели, то это не является поводом для беспокойства. Эти бактерии присутствуют у женщин всех возрастов, но наибольшее их количество наблюдается у молодых девушек, не приступивших к половой жизни. Раньше в мазке из влагалища на степень чистоты определяли лишь общее число кисломолочных микроорганизмов и называли их палочками Дедерлейна. С развитием современных медицинских технологий стало возможным выделение каждого вида бактерий, выяснилось, что значительное их количество – это Lactobacillus spp. Норма у женщин, ведущих половую жизнь, несколько ниже, чем у девочек. Тем не менее, она не должна быть ниже 10 6 КОЕ/мл.
Лактобациллы, как и другие микроорганизмы, имеют определённое количество, которое считается нормальным. На каждом участке слизистой оболочки пищеварительного тракта это значение отличается. К примеру, содержание лактобактерий в желудочном соке составляет лишь 10 2 –10 3 КОЕ/мл, в то время как толстая кишка содержит 10 6 –10 7 КОЕ/мл Lactobacillus spp. Норма этих микроорганизмов во влагалище является наиболее высокой, по сравнению с другими слизистыми оболочками. Поэтому при обнаружении лактобактерий в организме, необходимо точно знать их количественные показатели для каждого отдела. Нормофлора Lactobacillus spp – норма для здорового человека. Изменение количества лактобацилл в каком-либо отделе организма указывает на патологическое состояние.
Диагностика и лечение
В диагностических целях для анализа на качественный и количественный состав микрофлоры берутся мазки секрета из влагалища или соскобы эпителия влагалища у женщин, уретры у мужчин.
Качественный анализ ДНК Lactobacillus spp проводится серологическими методами. Чаще всего выполняется ПРЦ – полимеразная цепная реакция. Современные лаборатории располагают ПРЦ-тест системами, которые не только обнаруживают Lactobacillus spp, но и проводят их видовую идентификацию.
Используется и метод посева на питательных средах.
Стоит отметить, что у женщин нарушения биотопа во влагалище встречаются гораздо чаще, чем у мужчин в уретре. В норме в мазке не должно быть патогенных микроорганизмов, а палочек Дедерлейна должно находится в пределах 107-109 КОЕ/мл.
Результат может оказаться ложным, если анализ сдается в период менструаций или приема антибиотиков. Данные могут быть искажены и при проведении гигиенических процедур, а также использования свечей, мазей или спреев менее чем за сутки до сдачи биологического материала.
Если в анализах на Lactobacillus spp обнаружено нарушение их баланса, то незамедлительно необходимо начинать лечение. После интерпретации результата анализа врач назначит курс антибиотиков при наличии патогенного агента, а затем курс эубиотиков для восстановления нормального количества лактобактерий. Могут быть назначены витамины и иммуностимулирующие препараты.
Lactobacillus spp в мазке у женщин что это
Внутриматочная спираль Мирена – это популярнейший гормональный контрацептив. Подобная продукция применяется повсеместно еще с прошлого столетия и многим женщинам изделия сразу же пришлись по вкусу. Почему? Все из-за их положительных…
Во время гинекологического осмотра многие женщины, достигшие возраста 50 лет и находящиеся в климактерическом периоде, узнают о наличии у себя такого заболевания, как железистый полип эндометрия. Они сталкиваются с необходимостью…
Что делать при миоме матки? Причины возникновения и методы лечения
Согласно статистике, миоме (миоматозу матки) чаще всего подвержены женщины детородного возраста. Эта патология — доброкачественная опухоль, сформировавшаяся при гормональном дисбалансе, а также из-за ряда других факторов. Новообразования небольших размеров могут…
Миома матки при климаксе: симптомы и лечение
В период климакса происходит обострение хронических заболеваний, появляются новые патологии. Может развиться миома матки. По медицинской статистике такое заболевание поражает 20% женщин в окончания репродуктивного возраста. Полная информация о болезни…
Лечение большой миомы без операции. Народное лечение.
Сегодня мы поговорим о возможности лечения большой миомы без операции, что называется, «народными средствами». Эффективно ли это? способно ли помочь? В этой статье мы раскроем базовые принципы по этому вопросу,…
Цитология шейки матки. Что такое «Плохая цитология»?
Цитология шейки матки представляет собой процедуру микроскопического изучения клеток эпителия, которые были взяты со стенок шейки матки и цервикального канала. Её проведение должно быть обязательным для каждой женщины возрастом от…
Удаление матки лапароскопическим методом
Многие отчаявшиеся женщины не знают, что делать и испытывают стресс, когда выносит заключение — провести удаление матки лапароскопическим методом. Конечно, такой вердикт приводит в панику, ведь все-таки это – серьезная…
Повидон-йод — применение в гинекологии и не только!
Повидон-йод – антисептик с противомикробным, бактерицидным воздействием на вирусы, грибы простейшие, приведшие к развитию инфекции в кожных покровах. Действие препарата в отличие от неорганического йода – длительное. Вязкая жидкость темно-коричневого…
Что такое смешанная микрофлора в мазке у женщин?
Смешанная флора в мазке у женщин иногда диагностируется при проведении лабораторного исследования. Это один из видов анализа, позволяющий выявить патогенные микроорганизмы во влагалище, их численность, возможное развитие воспаления, также процентное…
Симптомы и лечение периметрита матки
Периметрит представляет собой воспалительный процесс серозного слоя матки. Данное заболевание развивается, если происходит распространение инфекции, под влиянием которой попадает не только матка, но и ее придатки. Каким может быть заболевание?…
О чем говорят коричневые выделения на разных сроках беременности?
Коричневые выделения при беременности нередко являются основной причиной для волнения, так как, по мнению многих женщин, представляют собой угрозу для развития плода. Период ожидания малыша редко проходит без волнений, ввиду…
Можно ли перепутать беременность с кистой яичника?
Киста яичника может образоваться у любой женщины и поначалу не проявлять каких-либо признаков, указывающих на её появление. Согласно статистическим данным большинство пациенток непреднамеренно перепутали беременность с кистой, что впоследствии привело…
Функции в организме
Лактобацилус spp в мазке – это одна из разновидностей лактобактерий, относящихся к естественной микрофлоре организма. Они обеспечивают нормальный метаболизм, поэтому постоянно присутствуют внутри человека. Лактобациллы относятся к грамположительным и аэробным микроорганизмам, у них нет способности образовывать споры.
Этот вид бактерий относится к группе молочнокислых палочек, а все благодаря способности перерабатывать лактозу и другие виды углеводов. Во время метаболических процессов бактерии выделяют лизоцим – это вещество, обладающее обеззараживающим действием, также выделяется перекись водорода и другие продукты обмена, оказывающих антибактериальное действие.
Но главное их свойство – образование молочной кислоты, которая останавливает развитие и размножение грибов и болезнетворных микроорганизмов.
Лактобацилус spp в мазке должны присутствовать обязательно, ведь без них флора влагалища не способна выполнять защитную функцию и тогда в ней будут развиваться инфекции и воспаления. Лактобактерии создают закисленную среду внутри влагалища, которая пагубно воздействует на патогенные организмы (кишечную палочку, стафилококк) – в ней они погибают.
Если в мазке большое содержание лактобацилл, то это говорит о крепком иммунитете и отсутствии признаков развития воспалительного процесса.
Существует несколько видов лактобацилл, которые могут населять не только влагалище, но и тонкий и толстый кишечник.
В желудочно-кишечном тракте эти виды микроорганизмов выполняют такие функции:
- стимулируют иммунную защиту;
- запускают регенерацию слизистых;
- участвуют в синтезе лактазы, интерферона и цитокина;
- активизируют выработку витаминов группы В и К.
на сегодняшний день учеными было открыто более 100 видов лактобактерий-лактобацилус, но самыми распространенными считаются:
- Lactobacillus casei – сырная палочка;
- Lactobacillus acidophilus – ацидофильный микроорганизм;
- Lactobacillus delbrueckii subsp. Delbrueckii – дельбрюковский организм;
- Lactobacillus bulgaricus – болгарская палочка, это компонент, входящий в состав натурального йогурта;
- Lactobacillus plantarum – молочнокислая бактерия.
Также существует огромное количество генетических подвидов микроорганизма или словами медиков – штаммов.
Информация об исследовании
Срок исследования увеличен до 8 дней.
Лактобактерии – представители облигатного бактериоценоза здорового человека, на их долю приходится около 10% нормофлоры. При изучении видового состава лактобактерий у здоровых людей разных возрастных категорий установлено, что лактобактерии доминируют у детей раннего возраста.
Во влагалище у 80% здоровых женщин число лактобактерийДодерляйна достигает 105-107/мл; обычно выделяют Lbm. casei, Lbm. acidophilus, Lbm. fermentum, Lbm. plantarum, Lbm. Brevis.
Лактобактерии оказывают существенное влияние на процессы обмена веществ, обеспечивают организм человека витаминами группы В, С, К, никотиновой и фолиевой кислотами, биотином, вырабатывают аминокислоты, молочную, уксусную и другие органические кислоты, антибиотико- и гормоноподобные вещества, перекись водорода, L. fermentum № 90T-C4 продуцирует эндогенный лизоцим.
Лактобактерии обладают набором свойств, которые позволяют конкурировать с условно-патогенными микроорганизмами и колонизировать определённый биотоп организма.
Аналитические показатели: специфичность определения – 98%.
Чувствительность метода – не менее 80 днк-копий в 5 мкл прошедшей обработку (выделение ДНК) пробе.
Материал для исследования: соскобы эпителиальных клеток из цервикального и уретрального каналов, со сводов влагалища, периуретральной области, крайней плоти.
У здоровых женщин репродуктивного возраста общее количество микроорганизмов в вагинальном отделяемом составляет 107-109 КОЕ/мл и состоит из более чем 40 разнообразных видов. Основная часть из них палочки Додерляйна, лактобациллы (Lactobacillus spp.): L. crispatus, L. jensenii, L. acidophilus, L. brevis. Число лактобактерий достигает 105-107 КОЕ/мл.
Лактобактерии оказывают существенное влияние на процессы обмена веществ, обеспечивают организм человека витаминами группы В, С, К, никотиновой и фолиевой кислотами, биотином, вырабатывают аминокислоты, молочную, уксусную и другие органические кислоты, антибиотико- и гормоноподобные вещества, перекись водорода, L. fermentum № 90T-C4 продуцирует эндогенный лизоцим.
Лактобациллы обладают способностью перерабатывать гликоген в молочную кислоту, продуцировать пероксид водорода, что позволяет поддерживать постоянство рН влагалища, снижая кислотность, при этом подавляется рост условно-патогенной микрофлоры. Исследование на Lactobacillus spp, методом полимеразной цепной реакции в режиме реального времени (Real-Time), направленно на выявление генетического материала (ДНК) для диагностики бактериального вагиноза. Этот метод характеризуется высокой специфичностью, быстрым получением результата. Он основан на многократном увеличении числа копий специфичного для данного возбудителя участка ДНК. Метод применяется для диагностики бактериального вагиноза – это инфекционный не воспалительный синдром, связанный с дисбиозом вагинального биотопа, который характеризуется количественным снижением или полным исчезновением лактобактерий, и резким увеличением облигатно- и факультативно анаэробных условно-патогенных микроорганизмов, наиболее часто это Gardnerella vaginalis, Atopobium vaginae, а также при назначении и контроле проводимой терапии. При оценке результата надо учитывать, что выявляются фрагменты ДНК как живых, так и разрушенных микроорганизмов, поэтому результат исследования будет оставаться положительным еще в течение некоторого времени, даже если лечение было подобрано правильно.
За 10 дней до взятия биоматериала необходимо прекратить прием лекарственных препаратов и лечебные процедуры.
Мазок для женщин: не проводится взятие материала в дни менструации.
Мазок для мужчин: перед исследованием воздержаться от мочеиспускания в течение 1,5-2 часов.
Как меняется биоценоз на протяжении жизни женщины
Для определённого периода жизни женщины характерно доминирование той или иной группы микроорганизмов. У новорождённой малышки микроорганизмы во влагалище начинают появляться на второй день жизни. Полученные от матери гормоны эстрогены поддерживают кислую среду во влагалище. Его стенки выделяют гликоген — полисахарид, являющийся прекрасной средой для размножения молочнокислых бактерий (лактобактерий, бифидум бактерий).
Условно-патогенные микроорганизмы появляются после третьей недели жизни, потому что иммунитет, полученный от матери, постепенно ослабевает
Защитные свойства биоценоза девочки не отличаются стабильностью, поэтому важное значение играет девственная плева, не впускающая внутрь патогенную микрофлору
В подростковом возрасте организм девушки сам вырабатывает эстрогены, поддерживающие оптимальную кислую среду во влагалище. Условно-патогенная микрофлора вымывается активно выделяющейся слизью. К 16 годам уже сформирован уникальный биоценоз, который сохраняется весь детородный период.
В возрасте от 16 до 45-50 лет (до наступления менопаузы) во влагалище здоровой женщины присутствует около 40 различных микроорганизмов, 95% которых относится к группе молочнокислых непатогенных, а 5% принадлежат к условно-патогенным.
Как определяют
Если есть хоть малейшее подозрение на снижение уровня лактобацилл в микрофлоре влагалища, то срочно следует посетить гинеколога. Современнейшие методики диагностики помогают быстро и точно установить количество лактобактерий и найти причину снижения их уровня.
Гинеколог во время осмотра пациентки берет мазок из уретры, влагалища и вульвы, а после отправляет его на микроскопическое исследование. Если после данного исследования становится ясно, что наблюдается дисбаланс, то проводят более точное исследование.

Максимально точной методикой является ПЦР. Это один из точнейших методов, суть которого заключается в использовании особых ферментов, многократно копирующих фрагменты РНК и ДНК болезнетворных микроорганизмов, находящихся в пробах биоматериала – мазке.
После получения данных лаборант сверяет полученные фрагменты с базой данных, выделяют вид возбудителя и его концентрацию.
Проводят исследование на специальном аппарате – амплификаторе, который нагревает и охлаждает пробирки с биоматериалом. Нагревание и охлаждение требуется для проведения репликации. Точность температуры непосредственно влияет на точность полученных результатов.
После все результаты вписывают в специальный бланк – ответ. Стоимость исследования от 500 руб.
23 ответа
Не забывайте оценивать ответы врачей, помогите нам улучшить их, задавая дополнительные вопросы по теме этого вопроса.Также не забывайте благодарить врачей.
Молчанова Елена Викторовнагинеколог 2017-03-23 12:54
Здравствуйте. Да. Дефицит нормальной флоры. Отсюда могут быть такие выделения
ВБ 2017-03-23 14:23
Елена Викторовна, большое спасибо за то что, ответили на мой главный вопрос. Подскажите, пожалуйста, так что же все таки нужно делать при дефиците нормальной флоры. Какая терапия? Спасибо
ВБ 2017-03-23 15:32
Елена Викторовна, большое спасибо за то что, ответили на мой главный вопрос. Подскажите, пожалуйста, так что же все таки нужно делать при дефиците нормальной флоры. Какая терапия? И чтобы безопастно было при беременности Спасибо
Молчанова Елена Викторовнагинеколог 2017-03-23 21:00
Можно обычный пробиотик:) банальный Линекс, йогурт, Бифиформ
Елена 2017-09-10 22:36
Добрый вечер. Беременность 32 неделя. Сдавала мазок на рост патогенной микрофлоры — не выявлен, но нашли lactobacillius spp — 10*3. Что это значит и опасно ли это для будущего ребёнка? Спасибо заранее за ответ!
Молчанова Елена Викторовнагинеколог 2017-09-11 09:30
Здравствуйте. Это нормальная флора. Ее просто мало — норма — от 10 в 6 степени.
Елена 2017-09-14 19:00
Спасибо огромное за ответ!
Молчанова Елена Викторовнагинеколог 2017-09-15 11:19
Всегда пожалуйста:)
Дарья 2018-10-20 16:19
Здравствуйте! Пожалуйста, помогите понять результаты анализов
Посев на флору и АЧ
1 Candida albicans 10^2 KOE/тамп
2 Lactobacillus sp. 10^3 KOE/тамп
Молчанова Елена Викторовнагинеколог 2018-10-20 18:53
Здравствуйте. Выложите, пожалуйста, фото.
Елизавета 2019-05-01 12:48
Добрый вечер!
Собираю анализы на ЭКО. Сдала БАК посев:
ПОСЕВ НА АЭРОБНУЮ И ФАКУЛЬТАТИВНО-АНАЭРОБНУЮ БАКТЕРИАЛЬНУЮ ФЛОРУ С
ОПРЕДЕЛЕНИЕМ ЧУВСТВИТЕЛЬНОСТИ К ОСНОВНОМУ СПЕКТРУ АНТИМИКРОБНЫХ ПРЕПАРАТОВ
Результат:
Микроорганизм Результат
Lactobacillus spp. 1 · 10в5
Заключение: В исследуемом биоматериале обнаружен рост сопутствующей микрофлоры, что не требует определения
чувствительности к антимикробным препаратам.
Роста патогенной и условно-патогенной микрофлоры в диагностически значимом количестве не обнаружено.
Подскажите, пожалуйста, это нормально?
Молчанова Елена Викторовнагинеколог 2019-05-01 12:58
Здравствуйте. Да, у Вас норма. Это нормальная флора
Татьяна 2019-10-14 16:33
Добрый день! Собираю анализы на ЭКО.
Пожалуйста, помогите понять результат посева на флору:
Обнаружен рост нормофлоры
Микроорганизмы рода Candida не выявлены.
Получен рост нормальной микрофлоры:
Lactobacillus sp. 10*3
Микоплазма и уреаплазма не обнаружены.
Молчанова Елена Викторовнагинеколог 2019-10-15 10:56
Здравствуйте. Получен рост нормальной флоры. В лечении Вы не нуждаетесь
Татьяна 2019-10-15 10:59
Спасибо большое за ответ!
Молчанова Елена Викторовнагинеколог 2019-10-15 11:09
Пожалуйста, здоровья Вам.
Лариса 2020-07-11 10:25
После лечения молочницы сдала анализ на бакпосев. Обнаружен обильный рост лактобактерий. Принимала целый месяц вагилак в капсулах во внутрь. Подскажите пожалуйста, не вызовет ли это снова молочницу? Патогенной флоры не обнаружено.
Молчанова Елена Викторовнагинеколог 2020-07-11 10:50
И Вам тоже добрый день, Лариса:)
Лариса 2020-07-11 12:03
Добрый день. Отвечать на вопрос не будете?
Молчанова Елена Викторовнагинеколог 2020-07-11 17:35
Добрый. Лариса, я отвечаю на все вопросы в порядке очереди. Первым делом — платные, потом — бесплатные. Но считаю, что врач-консультант достоин «здравствуйте» в любом случае:)
По сути. Приведите фото анализа для предметной консультации.
Лариса 2020-07-11 20:54
Добрый вечер. Анализ сделан через неделю после лечения молочницы (принимала Флуомизин 6 дней и вагилак в капсулах во внутрь около месяца) мог ли вагилак спровоцировать обильный рост лактобактерий.? Уточняю вагилак принимала в капсулах через рот. Сейчас беспокоит небольшой дискомфорт во влагалище, выделений обильных нет.
Лариса 2020-07-11 23:52
Елена Викторовна и второй вопрос, может ли быть цитолитический вагиноз в постменопаузе? По цитологии атрофический тип мазка.
Молчанова Елена Викторовнагинеколог 2020-07-12 11:13
— неясно, что такое «обильный рост». Важна цифра. Уточните. Потом что и 10 в 6 степени — это обильно. Но норма.
— не встречала в практике.
Enterobacterium spp норма у женщин
м. Кишинев, бул. Траян 7/1 карта
022 944 944 069 944 944 069 944 949
Пн — Пт с 7.30 до 19.00, Сб 8.00 — 13.00
Диагноз бактериального вагиноза ставится либо при определении клинико-лабораторных критериев Амселя, либо при определении баллов Нугента, либо при обнаружении так называемых высокоспецифичных маркеров (Atopobium vaginae, Clostridium spp.) бактериального вагиноза. В настоящее время, традиционным методом этиологической диагностики любого инфекционного процесса является культуральный метод. Однако этот способ имеет ряд серьезных недостатков:
Объективные и субъективные ограничения методов лабораторной диагностики, применяемых сегодня в мировой медицинской практике, приводят к большому количеству диагностических ошибок: при манифестированном БВ – более чем в 60%, при кандидозном вульвовагините – до 77%; при микст-инфекции – до 87% (Schwiertz A. et al. 2006). С другой стороны, невысокая чувствительность критериев Амселя и наличие бессимптомных форм бактериального вагиноза заставило искать другие методы и критерии подтверждения диагноза.
Новый метод исследования микробиоценоза влагалища методом ПЦР – уникальное исследование, позволяющее наиболее полно и точно охарактеризовать качественный и количественный состав биоценоза влагалища. Достоинством нового метода является возможность исследовать нормофлору, наличие, степень и характер дисбаланса условно-патогенной инормальной флоры.
Показания к применению метода
Данная технология предусматривает возможность анализа ряда показателей
Контроль взятия биоматериала
Общая бактериальная масса
Аэробные микроорганизмы (факультативные анаэробы)
- Enterobacterium spp.
- Streptococcus spp.
- Staphylococcus spp.
Анаэробные микроорганизмы (строгие анаэробы)
- Mycoplasma (hominis +genitalium)
- Ureaplasma (urealyticum + parvum)
Интерпретация полученных результатов
В норме LB являются главной составляющей ОБМ, поэтому абсолютный показатель уровня лактобацилл практически не отличается от абсолютного показателя общей бактериальной массы и соответствует 10 6 –10 8 для вагинальных соскобов, для уретры и цервикального канала – на порядок меньше – 10 5 – 10 7 .
Аэробные и анаэробные условно-патогенные микроорганизмы
Абсолютный показатель 10 4 , относительный показатель – меньше -3 (0,1%), отдельные представители условно-патогенной микрофлоры могут иметь относительный показатель от -3 до -2 (0,1%-1%) – слабо увеличенный уровень.
Отсутствуют или их абсолютный показатель 10 4 .
Отсутствуют или их абсолютный показатель 10 3 .
ДИСБАЛАНС I (умеренный)
Общая бактериальная масса
Абсолютный показатель 10 6 -10 8 для влагалища, 10 5 -10 7 – для уретры и цервикального канала.
Абсолютный показатель 10 6 -10 8 , 10 5 -10 7 – для уретры и цервикального канала; относительный показатель – от -0,3 до -1 (70%-10%).
Аэробные и анаэробные условно-патогенные микроорганизмы
Абсолютный показатель 10 4 , относительные показатели различных условно-патогенной микрофлоры варьируют от -3 до -1 (0,1%-10%).
В норме отсутствуют или абсолютный показатель 10 4 .
В норме отсутствуют или абсолютный показатель 10 3 .
ДИСБАЛАНС II (выраженный)
Общая бактериальная масса
Абсолютный показатель может варьировать от полного отсутствия лактобацилл до значений 10 5-6 (как правило во влагалище количество лактобацилл на 1 порядок выше, чем в уретре и цервикальном канале); относительный показатель – меньше -1 (0-10%).
Аэробные и анаэробные условно-патогенные микроорганизмы
Могут отсутствовать или абсолютный показатель 10 4 .
Отсутствуют или абсолютный показатель 10 3 .
Классификация дисбалансов в зависимости от этиологической структуры
Дисбаланс, вызванный преимущественно аэробными микроорганизмами: Enterobacteraceae, Streptococcus spp и Staphylococcus spp.
Дисбаланс, вызванный сочетанием аэробной и анаэробной бактериальной биоты, возможно в сочетании с дрожжевыми грибами рода Candida.
Программное обеспечение позволяет автоматически анализировать полученные данные и выдавать заключение в удобном для интерпретации виде. Метод предназначен как для повседневной лабораторной диагностики, так и в качестве чувствительного и высокоспецифичного инструмента для научных исследований.


















































